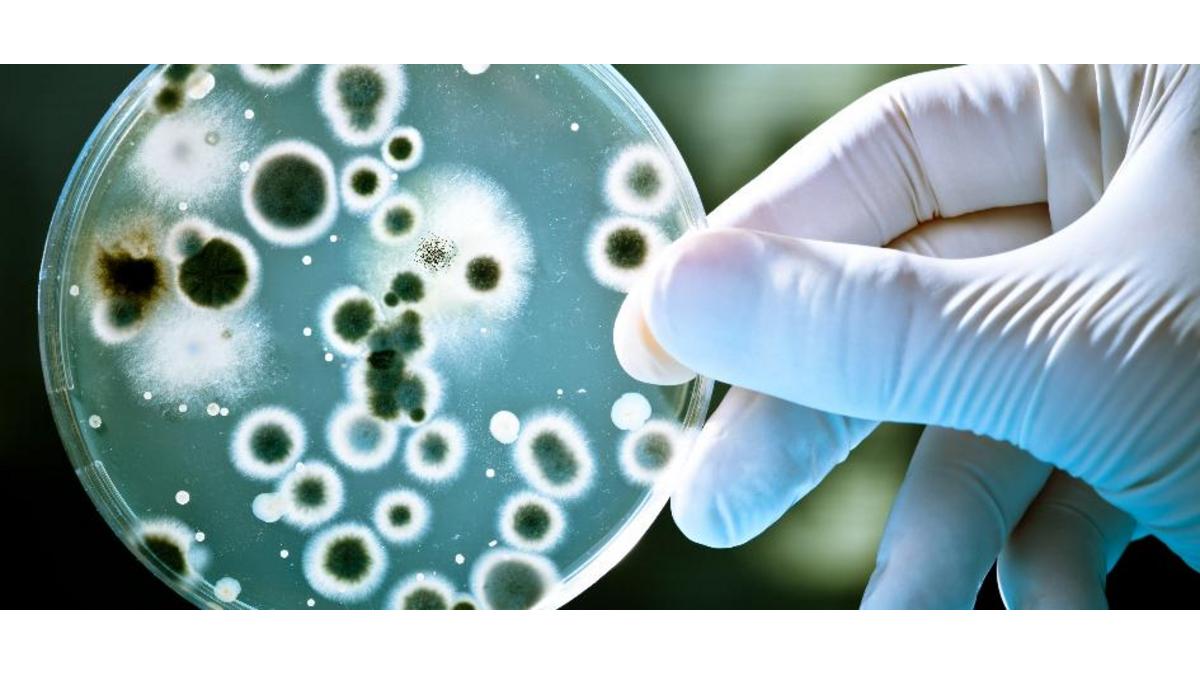

Membres
EP Equity Investment (EPEI) et Nanobacterie annoncent un partenariat stratégique
Une prise de participation de 24,99% dans cette start-up française, dont la filiale AlphaOnco Swiss SA a été accompagnée par la CCI France Suisse.
La start-up française Nanobactérie, et sa filiale valaisanne AlphaOnco Swiss SA, que le Service implantations de la CCI France Suisse a accompagné en 2022 dans son installation au BioArk en Valais, en partenariat avec le GGBa, a obtenu un investissement stratégique d’EP Equity Investment.
Ce partenariat communiqué le 30 avril 2024, marque une étape importante pour Nanobacterie afin d'accélérer le développement de son traitement innovant non invasif du cancer. Edouard Alphandéry, fondateur de Nanobacterie, a déclaré que l'investissement d’EP Equity Investment est "essentiel à ce stade crucial de notre développement, afin de pouvoir lancer la phase des essais cliniques".
La CCI France Suisse félicite vivement Edouard Alphandéry pour cette avancée majeure et lui souhaite le meilleur succès pour tous les développements à venir !
